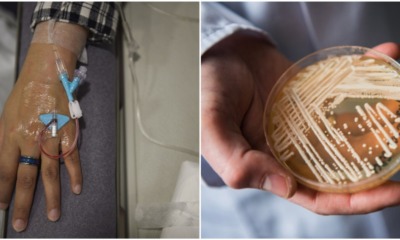
This Fungal Infection is Drug-Resistant, Can Kill You in 90 Days, and Has Spread Worldwide - WORLD OF BUZZ

As the end of the year is fast approaching, many of us could not be more excited to pack up and leave for our holidays! Amidst...


Man, the KLCC is still out of sight but the haze just can’t get outta our mind. It’s getting worse! According to The Star, our Health...


Oh damn! Berita Harian shared the latest pictures of the KL (Kuala Lumpur’s) iconic skyscraper – the Petronas Towers aka KLCC – on their Facebook page...


Just take a look outside and you can barely see anything, thanks to the thick haze that has been the bane of our lives these past...


When H1N1, a subtype of the Influenza A virus first reared its head in 2009, Malaysians were sent into a state of panic as the virus...


Even though cancer treatment methods have progressed greatly, the diagnosis of cancer can still feel like a death sentence to many, not least of all because...

Even though medical technology has come a long way, the viruses and infections that were invented to treat/prevent them have too. One of the most recent,...


Prime Minister Tun Dr Mahathir Mohamad is a man pressed for time. According to Malaysiakini, the 93-year-old premier said that he does not have long left...


A cup of tea can do so much for one’s mood, whether it’s as a refreshing start to the day or a soothing balm at the...


Lately, many people who are against the idea of vaccination have been opting to not vaccinate their kids and their refusal has caused a rise in infectious...


Sometimes, after a long day at work, it can be hard to muster up the energy to prepare dinner for yourself and we would turn to...


Most of us have thought about leaving our city life behind and moving to a remote island to be surrounded by nature’s beauty. However, not many...


To all makeup enthusiasts out there, you might want to filter through your makeup kit after reading this! Korea’s Ministry of Food and Drug Safety recently...


If someone told you that there was a magical herbal tree that could cure all types of illnesses, would you believe them? More importantly, would you...


Many of us people from younger generations probably find it hard to commit to a partner. Thanks to advancement in technology, we use ‘dating’ apps such...


Babies are fragile creatures who need extra care and attention. Putting them in a risky situation even for 5 seconds can lead to serious consequences. A...